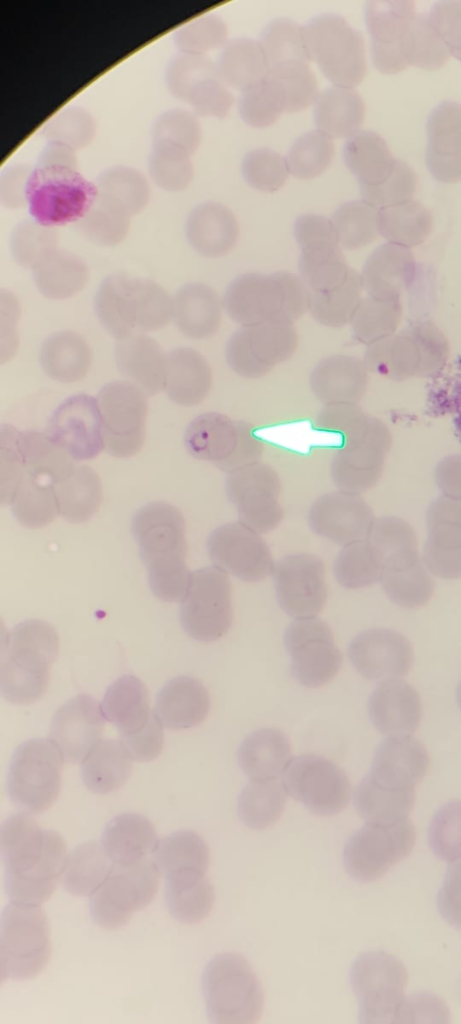
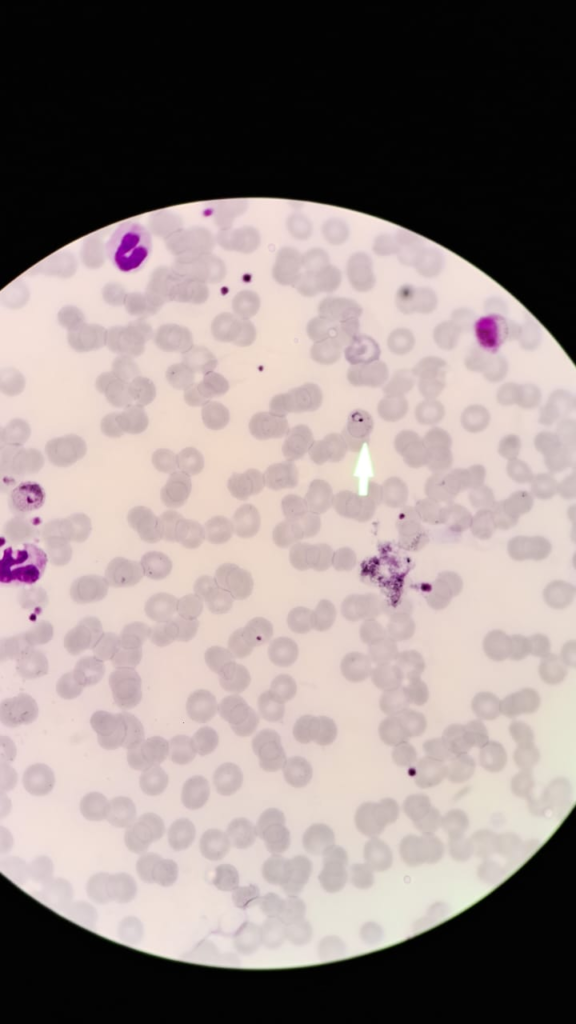
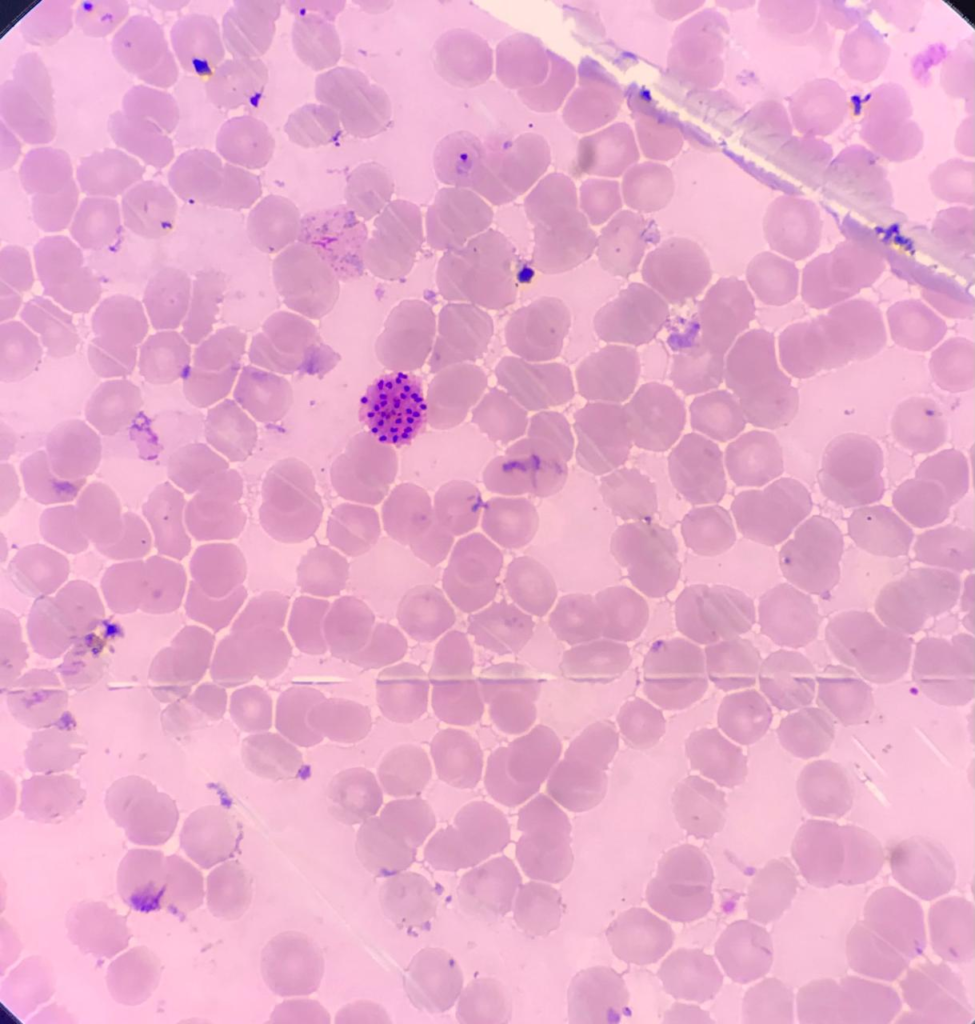
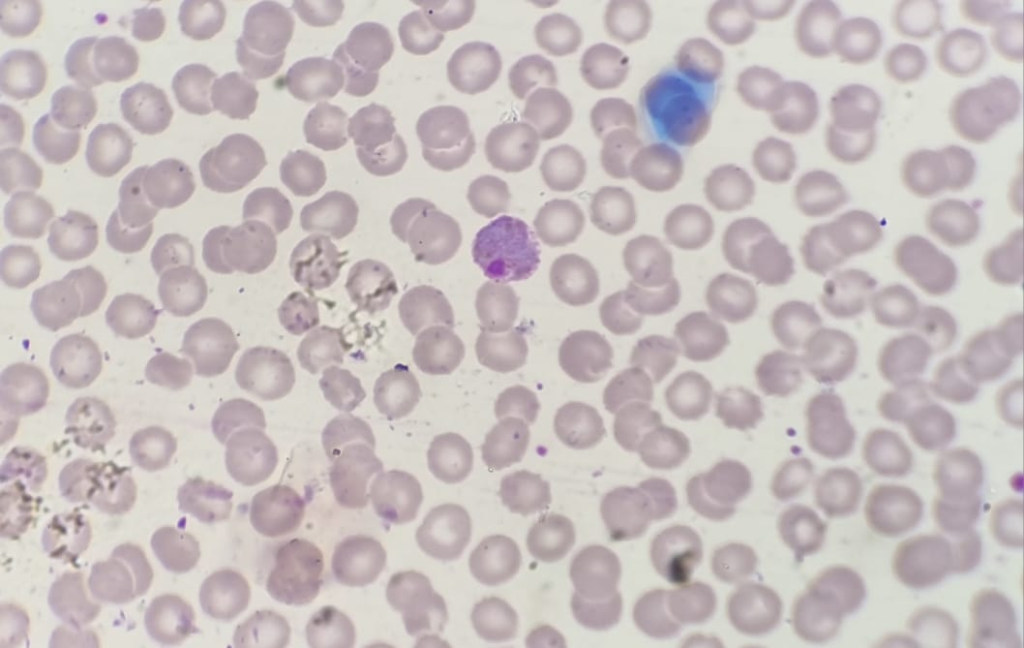

Morphology of Plasmodium Vivax
This parasite was discovered by Grassi and Feletti in 1890. The name “vivax” was given to the species because of its amoeboid nature. P. vivax causes a disease in humans called benign tertian malaria.
- Benign means it is rarely fatal.
- “Tertian” means the fever recurs every 48 hours.
This parasite shows a greater tendency to invade younger red blood cells (RBCs).
There are mainly four stages found in peripheral blood smears

1) Ring stage
A small, compact red dot of chromatin surrounded by blue cytoplasm, which looks like a ring. The cytoplasm contains a vacuole and is comparatively thicker than in P. falciparum. The ring measures about one-third of the normal RBC.
Infected RBCs enlarge only in P. vivax (not in P. falciparum), and pseudopodia may occasionally be seen.
2) Trophozoite
- Develops in about 5–6 hours.
- May assume irregular shapes in enlarged RBCs.
- The growing parasite has pseudopodia.
- The chromatin is red-colored and slightly larger than in the ring stage.
- One or more vacuoles are present in the cytoplasm.
- Hemozoin (pigment) appears as yellowish-brown granules.
- Fine red-colored stippling, known as Schüffner’s dots, is present.
3) Schizont
a) Early schizont: After 36–40 hours, the parasite almost fills the RBC, which becomes twice its normal size. Division of the nucleus (chromatin) produces 12–24 small chromatin dots, and the cytoplasm becomes diffused.
b) Mature schizont: After chromatin division, cytoplasmic division starts. Each chromatin dot acquires cytoplasm, forming 12–24 individual parasites called merozoites. Pigments collect in one or more loose masses: peripheral in early schizonts and central in mature schizonts.
4) Male gametocyte
Contains less cytoplasm and stains lightly (faint). It appears grayish-blue or pinkish-blue. The nucleus (chromatin) is diffused, centrally placed, and shows a reticular distribution.
5) Female gametocyte
Also called the macrogametocyte.
- Stains blue.
- Chromatin is compact and usually situated near the periphery of the parasite.
- The gap between cytoplasm and chromatin is called the zone of carolymph, found only in female gametocytes.
- Chromatin is larger than in male gametocytes.

